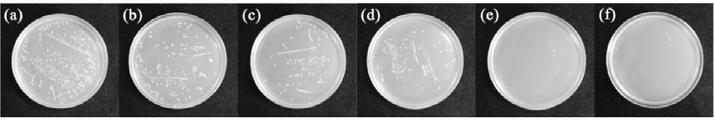

Fotokatalýza je jev, který vzniká spontánně v přírodě. Stejně jako při fotosyntéze, světlo a vlhkost prostředí hraje důležitou roli při eliminaci škodlivin přítomných ve vzduchu, který dýcháme
V roce 1972 profesoři Akira Fujishima (1942 - ) a Kenichi Hond (1925 – 2011) zaměřili své studie na specifikum určitých minerálů, které reagují na světlo. Ve stejném roce napsali průlomovou publikaci nazvanou Electrochemical Photolysis of Water at Semiconductors Electrodes (Nature 238, 37-38), ve které odhalili mechanismus působení oxidu titaničitého (TiO2), známého fotokatalytického minerálu, při rozkladu vody působením slunečního světla. Tento objev nastartoval revoluci ve výrobě keramiky, skla a jiných odvětvích

Z této studie bylo vyvinuto nespočet povrchových použití v několika odvětvích s různými výsledky
Vzhledem k této široké rozmanitosti použití bylo vyvinuto několik norem ISO k regulaci a standardizaci postupu ověřování, který prokazuje fotokatalytickou aktivitu minerálu.























Tento vynález spočívá ve speciálním postupu získávání fotokatalytického polymeru prostřednictvím vývoje fotokatalytického pojiva. Pokud se tato přísada přidá k akrylové pryskyřici, získáme umělý kámen s fotokatalytickou aktivitou.
Dalším aspektem tohoto vynálezu je to, že výsledný polymer má vysokou katalytickou homogenitu, což znamená, že fotokatalytické částice působí všude na povrchu materiálu, a navíc i v celé jeho tloušťce
Během výrobního procesu se smíchávají bíle zbarvené fotokatalytické minerály pro dekorativnější účely, jako je například TiO2 rutil, ZnS, SnO2 nebo ZnO, s aktivnějším fotokatalyzátorem, jako je například TiO2 anatas. TiO2 rutil a TiO2 anatas jsou dva odlišné fotokatalyzátory s různými aktivačními energiemi
Tato směs minerálů je dále rozpuštěna společně s hliníkovým trihydroxidem a siloxanem ke zvýšení fotokatalytické aktivity a vytvoření přísady, která se může následně inkorporovat do výrobního procesu materiálu Krion®

Ještě před přidáním silanu a siloxanu se směs přesívá, čímž dochází k eliminaci částic menších než 0,5 μm a zabraňuje se tak tomu, aby byly některé částice při vdechnutí nebezpečné
Výsledný polymer má vysokou katalytickou homogenitu s fotokatalytickými částicemi působícími na všech druzích povrchu materiálu. Výsledkem je to, že může dojít k reakcím na povrchu základního polymeru včetně rozkladu těkavých organických látek (VOC), rozkladu toxických plynných látek (NOx, SOx…), organických rozpouštědel (benzen, toluen...) a dalších škodlivých látek (formaldehyd, acetaldehyd...). Mimo to získává materiál také antibakteriální vlastnosti a je schopný nejenom zamezovat šíření bakterií, ale dokonce je i aktivně eliminovat. Dále jde o povrch, který se snadno čistí, což je důsledkem vytvoření superhydrofilních vlastností. V případě, že je povrch v kontaktu s kapalinou, jako je voda nebo olej, fotokatalytický proces modifikuje úhel kontaktu a tyto kapky tak hůře drží na povrchu materiálu

Vzhledem k polymerickému charakteru vynálezu se může materiál použít uvnitř i venku. Materiál se také snadno čistí, opravuje, je pevný a dlouhodobě barevně stabilní, hygienický, odolný vůči nárazu, skvrnám, teplu či teplotním změnám. Jeho fotokatalytická aktivita se během času nesnižuje ani nepodléhá opotřebení. To všechno je jen krátký výčet výhod Krion®
Tento patentovaný vynález je platný po dobu 20 let od data předložení

ISO 27448:2009

Pro ilustraci této vlastnosti byl proveden test výpočtu úhlu smáčení na Krion® K·Life 1100 v souladu s ISO 27448:2009 „Měření kontaktu smáčení vodou” v akreditované mezinárodní laboratoři Photocatalyst Standards Testing Centre (IPS), podle mezinárodních norem
Vlastnost snadného čištění nebo samočištění je stanovena v normě ISO 27448:2009 a chápána jako snadnější odstraňování škodliviny z povrchu fotokatalytického materiálu ve srovnání s jiným materiálem, který tuto vlastnost nemá, a to měřením úhlu smáčení vodou
Podmínky experimentu
Podle předpisů můžeme vyhodnotit fotokatalytický efekt materiálu, pokud je schopný modifikovat úhel smáčení svého povrchu při ozáření UV světlem Efekt vzniká v důsledku změny smáčivosti povrchu vlivem účinku záření
Tato změna je známa jako superhydrofóbní efekt v důsledku fotoindukce. Tento efekt definuje fotokatalytickou aktivitu materiálu na modifikování úhlu smáčení malou kapkou umístěnou na povrchu jako funkci času V provedeném testu se měří počáteční úhel smáčení, a poté znovu po 48 hodinách Podle pravidel tohoto testu jsou testovány dva vzorky Krion® K·Life 1100 a jejich výsledky jsou porovnány s testem vzorku vysoce samočisticího materiálu a vzorku rovného, nefotokatalytického skla


Pro tuto studii bude fotokatalytický rozklad prováděn s produkty, které jsou běžně v kontaktu s umělým kamenem při jeho každodenním používání
Tuto studii provedl Institut chemických technologií ve Valencii.

Za prvé, máme řadu sloučenin představujících běžná barviva:
Alizarin je sloučenina hojně používaná jako načervenalé barvivo, které je zvláště běžné v barvách na vlasy
Chlorofyl je sloučenina, která se nachází v rostlinách a/nebo zelenině a je obecně známá pro svou nepostradatelnou úlohu při fotosyntéze
Nikotin, obecně známý pro svou přítomnost v cigaretách
Krev. Hematoporfyrin je molekula nacházející se v krvi s typicky hnědou barvou
Rajče, jeden z hlavních původců skvrn nacházejících se v naší kuchyni


Cílem tohoto projektu je zaznamenat fotokatalytickou aktivitu vzorků Krion® K·Life 1100, materiálu společnosti KRION, v porovnání s běžným pevným povrchem, a to pořízením grafických dokumentů, které prokazují účinnost těchto prvků.



Jak jsme viděli, použití materiálů Krion® s technologií KEAST značně urychluje rozklad
běžných skvrn, a to pouhou přítomností světla
Grafické důkazy ukazují, že působení této technologie může rozložit některé z těchto látek během 24 hodin, zatímco jiné vytrvalejší potřebují několik týdnů

Krion® K·Life 1100 dosahuje určitých úrovní bělosti, které nejsou obvyklé u jiných materiálů typu Solid Surface. Tyto úrovně se považují za velmi blízké tomu, co se chápe jako teoreticky tzv. dokonalá bílá
POZNÁMKA: Tyto hodnoty jsou schváleny laboratořemi KRION v souladu s mezinárodními normami a pomocí kalibrovaných měřicích zařízení (spektrofotometr BYK model Sphere Gloss & X-Rite Ci6x UV).
95,37
Světelnost (L) je stupeň světla, které je jakákoliv barva schopna odrážet, přičemž 0 znamená dokonale černá a 100 dokonale teoreticky bílá.






Tloušťka 3 mm
2500x760x3mm
2500x930x3mm
Tloušťka 6 m m
2500x760x6mm
2500x930x6mm
2500x1350x6mm
3680x760x6mm
3680x930x6mm
3680x1350x6mm
Tloušťka